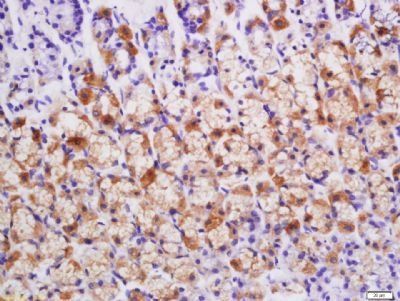
产品细节图片2

研选同类产品更多 >
万千商家帮你免费找货
0 人在求购买到急需产品
- 详细信息
- 用户评价
- 文献和实验
- 技术资料
- 抗体名:
BMP2 antibody
- 抗体英文名:
BMP2 antibody
- 靶点:
BMP2
- 浓度:
1mg/ml
- 应用范围:
ELISA, FC, ICC, IF, IHC-Fr, IHC-P, WB
- 宿主:
Rabbit
- 适应物种:
Human, Mouse, Rat
- 保质期:
6-12个月
- 抗原来源:
详询
- 目录编号:
orb182463
- 级别:
科研
- 库存:
99
- 供应商:
Biorbyt
- 标记物:
Unconjugated
- 克隆性:
Polyclonal
- 保存条件:
低温
- 形态:
Liquid
- 亚型:
IgG
- 免疫原:
KLH conjugated synthetic peptide derived from human BMP2
- 规格:
50 ul
产品名:BMP2 antibody
货号:orb182463
产品中文名:BMP2 抗体
Western blot analysis of mouse Eye lysates (Lane 1) using BMP2 antibody.
Immunohistochemical staining of rat stomach tissue using BMP2 antibody.
武汉博欧特生物科技有限公司为英国品牌Biorbyt中国办事处,即biorbyt中国总代理,即biorbyt总代。负责biorbyt品牌产品在中 国市场的推广、销售及售后服务。为您提供各种biorbyt原装进口产品,主推四 大类:
一. 抗体(antibody):24万种的一抗。 可应用于Western blot,IP,IHC,IF,FACS,ELISA等实验。
二. 蛋白(protien):3.6万种的高纯度蛋白 。
三. elisa试剂盒(elisa kit):可以提 供超过1.5万种的ELISA试剂盒,包括人源,大鼠源,小鼠源等。
四. 小分子(Small Molecules):超过 1.5万种的生物活性小分子,主要包括:拮抗剂、抑制剂、抗生素、天然产物。
所有biorbyt品牌的抗体,蛋白,elisa试剂 盒,小分子等产品国际航空低温运输,货期短,多数产品货期在1~两周,快捷 便利。
我们为研究者们提供免费的专业的售前售中 售后服务,为您的实验保驾护航。
公司对外诚接特色技术外包服务如下:
重组蛋白表达与纯化服务、单克隆抗体定制 服务、多克隆抗体定制服务、免疫学检测服务、动物实验技术服务。我们为客户 提供详实的生物信息咨询和全方位的可行性分析方案,为您的科研项目保驾护航 。
风险提示:丁香通仅作为第三方平台,为商家信息发布提供平台空间。用户咨询产品时请注意保护个人信息及财产安全,合理判断,谨慎选购商品,商家和用户对交易行为负责。对于医疗器械类产品,请先查证核实企业经营资质和医疗器械产品注册证情况。
用户评价
暂无用户评价
文献和实验又一个心脏干细胞?斯坦福 Nature 子刊报道关节炎骨骼干细胞疗法
再与 BMP2 和 sVEGFR1 联用是一种潜在的关节炎治疗方法。 研究意义: 该研究不仅证明了 SSC 在软骨再生中的重要作用,还是第一个通过骨骼中的 SSC 以及细胞命运控制实现有效且稳定软骨再生的报道。与此同时,该研究还提示了通过微骨折手术激活 SSC 并与 BMP2 以及 VEGF 抑制分子一起治疗关节炎的临床价值。更加值得注意的是,FDA 早已批准了 BMP2(Infuse) 和 VEGF 抗体(Avastin) 在其他疾病中的临床使用,这将使得相关临床试验所需的时间被大大缩短。 延伸阅读
Cardiac Commitment of Embryonic Stem Cells for Myocardial Repair
of the transforming growth factor (TGF)-β superfamily. We describe a protocol designed to turn on expression of cardiac-specific genes in undiffer entiated murine ES cells stimulated with BMP2 and/or TGF-β. Cell commit ment results in a significant improvement
In Vitro Derivation of Chondrogenic Cells from Human Embryonic Stem Cells
including BMP2 and TGFβ1 direct chondrogenic differentiation and modulate cartilage-specific matrix gene expression in a distinctive manner. Furthermore, a high percentage of differentiated cells exhibit typical morphological characteristics of chondrocytes










